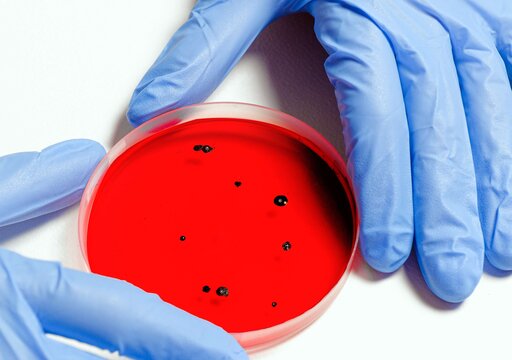

Medizinprodukte sind essentielle Produkte für die Patientenversorgung. Durch ihr Einsatzgebiet im und am Körper bestehen aus hygienisch-mikrobiologischer Sicht hohe Anforderungen. Diese Anforderungen steigen stetig und sind vor allem in der EU-Medizinprodukteverordnung verankert. Wir unterstützen Sie mit hochqualitativen und individuell zugeschnittenen Labordienstleistungen, damit Sie diese Anforderungen erfüllen können. Unsere Laboratorien sind für die Untersuchung von Medizinprodukten von der DAkkS nach DIN EN ISO/IEC 17025 akkreditiert und GLP-zertifiziert.
Wiederaufbereitungsvalidierung
Laborprüfungen
Der Gesetzgeber verpflichtet Hersteller von wiederaufbereitbaren Medizinprodukten, einen entsprechenden Prozess zur Wiederaufbereitung anzugeben. Dieser Prozess muss gemäß ISO 17664-1 und -2 validiert sein. Wir validieren bei Dr. Brill + Dr. Steinmann mit unserem umfangreichen Know-how manuelle und maschinelle Aufbereitungsprozesse für wiederverwendbare Medizinprodukte. Dabei führen wir gerne ein vom Kunden vorgeschlagenes Prozedere aus.
Unsere Zertifizierungen
Biokompatibilität
Laborprüfungen
Regularien wie die MDR fordern den Nachweis der Biokompatibilität aller Materialien, die mit Patienten oder Anwendern direkt (ISO 10993) oder indirekt (ISO 18562) in Kontakt kommen. Wir begleiten unsere Kunden gerne auf diesem Weg und führen Laborprüfungen durch (z.B. Zytotoxizitätstests nach ISO 10993-5 an neuen oder durch diverse Zyklen der Wiederaufbereitung gealterten Medizinprodukten, ISO 10993-23), um etwaig fehlende Informationen für die Risikobeurteilung zu erstellen. Sind wir nicht in der Lage, notwendige Testungen bei uns im Haus anzubieten, übernehmen wir bei Dr. Brill + Dr. Steinmann auch gerne für Sie die Projektkoordination mit Drittlaboren für Sie. Sie kontaktieren uns und wir machen den Rest.

Materialkompatibilität
Bei der Konzeption von Medizinprodukten sind neben funktionalen Fragen auch Sicherheitsaspekte zu berücksichtigen. So sollte beispielsweise die erwartete Lebensdauer nicht nur für den Einsatz am Patienten gelten, sondern auch im Hinblick auf die physikalischen und chemischen Verfahren, denen das Produkt voraussichtlich bei der Aufbereitung ausgesetzt ist. Zu diesem Zweck können wir für Sie auf einer ganzen Palette von verschiedenen Werkstoffen die Materialkompatibilität eines chemischen Verfahrens prüfen. Darüberhinaus können wir bei Dr. Brill + Dr. Steinmann auch ganz praktische Fragestellungen für Sie erörtern. Wenn Sie beispielweise wissen möchten, wie sich das Material Ihres spezifischen Produktes nach mehreren Zyklen der chemischen Behandlung verändert, stellen wir auch das gerne für Sie nach und testen im Anschluss, wie sich eine praxisnahe Behandlung ggf. auf die Zytotoxizität (ISO 10993-5) auswirkt.
Hygiene in Produktion und Labor
Hygienemonitoring
Auch für das hygienische Monitoring stehen wir Ihnen bei Dr. Brill + Dr. Steinmann gerne zur Verfügung. Unsere erfahrenen Außendienstmitarbeiter kommen gerne zu Ihnen und nehmen Proben, die der Keimzahlbestimmung von Oberflächen (Tupfer und Abklatsch) sowie der Luft (aktiv/Luftkeimsammler und passiv/Sedimentationsplatten) dienen. Im Dienstleistungspaket enthalten ist die Inkubation und Auswertung von Umgebungsproben. Darüber hinaus ist auch eine Keimidentifikation möglich. Falls Interesse besteht, können diese Daten dann auch durch unsere Partnerlabore zur systematischen Verfolgung von Kontaminationen genutzt werden. So haben Sie alles in einer Datenbank und können mögliche Kontaminationsquellen effektiver bekämpfen. Diesen Service können Sie selbstverständlich auch in Verbindung mit einer Desinfektionsvalidierung in Anspruch nehmen. Sprechen Sie uns gerne an!
Hygiene im Gesundheitsbereich
In Kooperation mit der Firma IDEXX bieten wir die Einführung und Überwachung von Hygienemanagementsystemen für Veterinärkliniken und Tierarztpraxen an. Die Leistungen umfassen, die Begehung der Einrichtung, die Erstellung von Statusberichten mit Verbesserungsvorschlägen, die Schulung der Mitarbeiter, die Erarbeitung eines individuellen Hygienehandbuches. Wenn die Hygienequalität unseren Anforderungen entspricht stellen wir auf Wunsch ein Hygiene-Zertifikat aus, welches Sie auf Ihrer Website, in Ihren Räumen usw. für Marketingzwecke nutzen können.
Hygiene in Produktion und Labor
Desinfektionsvalidierung
Pharmaunternehmen müssen bei einer Änderung im Reinigungs- und Desinfektionsprozedere im Produktionsprozess aufwändige Validierungen durchführen, um zu belegen, dass das neue oder veränderte Verfahren funktioniert. Mit der Identifikation von Hauskeimen, die in der Produktion isoliert werden konnten, in Kombination mit Oberflächenmaterialien aus der Praxis, kann im Labor die Desinfektionsleistung eines neu einzuführenden Desinfektionsmittels validiert werden. Wir validieren Ihre Reinigungs- und Desinfektionsprozess in Ihrer Produktion z.B. wenn es Änderungen im Prozess geben soll oder ein neuer Produktionsbereich in Betrieb genommen wird. Dabei bringen wir unsere Expertise aus dem Bereich der Desinfektionsmittelwirksamkeitsprüfung sowie der Aufbereitungsvalidierung von Medizinprodukten gern ein. Wir können bei Dr. Brill + Dr. Steinmann Flächendesinfektionsverfahren auf Basis der EN 13697 ohne Mechanik aber auch mit Mechanik und dem Einsatz von z. B. Tüchern auf Basis der EN 16615 für Sie validieren. Wir sammeln auch gerne vor Ort die für Sie relevanten Hauskeime im Rahmen eines Hygienemonitorings als Dienstleistungspaket. Kommen Sie also gerne mit Ihrer Anfrage auf uns zu.
Hygiene in Produktion und Labor
Hygieneservice Bioindikatoren
Sie suchen nach passenden Bioindikatoren für Ihren RDG(E), Waschmaschinen oder Geschirrspülmaschinen? Wir konzipieren bei Dr. Brill + Dr. Steinmann für die unterschiedlichsten Anwendungen Bioindikatoren und bieten Ihnen selbstverständlich auch die mikrobiologische Auswertung nach deren Nutzung an (DIN EN ISO 11138, DIN EN 13060, DIN EN ISO 18472, DIN EN 13060). Nehmen Sie also gerne Kontakt zu uns auf und erfragen die unterschiedlichen Paketleistungen, die wir für Sie etabliert haben.
Antimikrobielle Medizinprodukte
Desinfektionsmittel und Wundauflagen
Ihr Medizinprodukt ist ein Instrumentendesinfektionsmittel? Kontaktieren Sie uns gerne, denn wir prüfen die Wirksamkeit Ihrer Desinfektionsmittel z.B. nach EN 14561/2/3 und EN 17111. Auch Ihrer Reinigungsmittel können Sie bei uns testen lassen.
Ihr Produkt ist für die antimikrobielle Wundbehandlung gedacht? Auch hier können wir helfen und beispielweise nach EN 17854 testen. Neben der klassischen Normentestung haben wir zum Thema Wunde auch weitere einzigartige Verfahren (z.B. 3D Hautmodell) etabliert, von denen Sie als Kunde von Dr. Brill + Dr. Steinmann profitieren können.
Antimikrobielle Medizinprodukte
Biofilme
Der Kampf gegen Biofilme ist angesichts regulatorischer Unsicherheiten einerseits und technischen Herausforderungen andererseits für viele Hersteller von Desinfektionsmitteln eine große Herausforderung. Wir bei Dr. Brill + Dr. Steinmann haben durch die Entwicklung und Etablierung diverser Modelle im Hinblick auf Biofilme aber eine große Expertise, auf die Sie zurückgreifen können. Profitieren Sie von diversen technischen Möglichkeiten, die im Kontext von Biofilmen nützliche Erkenntnisse bringen können. Unter anderem können wir Ihnen folgende spezifische Dienstleistungen für Ihr Medizinprodukt anbieten:
- ISO/TS standard 15883-5: 2006, Annex F bzw. der Methode nach Pineau et al. 1997 (z.B. für flexible Endoskope)
- Hausmethode nach Brill et al. 2018 (z.B. für Katheterspüllösungen oder ausgerüstete Katheter)
- Methode nach Stürmer et al. 2021, 2022 (z.B. für Biofilme in Wunden)
Oft sind aber Verfahren speziell für Ihre Anwendung und Ihr Produkt zu entwickeln oder anzupassen. Das machen wir sehr gerne mit Ihnen. Wenn Sie also Bedarf haben, informieren wir Sie gerne im Detail dazu.
Klinische Studien an Proband*innen mit mikrobiologischen Endpunkten
Das Angebot in unserem Phase 1-Studienzentrum in Hamburg bezieht sich insbesondere auf Studien zum Nachweis einer antimikrobiellen Wirkung von Produkten, die auf die unverletzte Haut oder Schleimhaut aufgebracht werden sowie auf Untersuchungen zum Hautmikrobiom und deren Veränderung durch die Applikation von Produkten (Weitere Information). Endpunkte können Gesamtkeimzahl sein oder auch die Veränderung von zuvor artifiziell aufgebrachten Organismen bis hin zur Mikrobiomforschung. Sind Ihre Produkte “microbiom friendly”? Falls nicht, wird es vielleicht Zeit.
Bereits seit über 20 Jahren führen wir Prüfungen insbesondere zur Wirksamkeit von Händedesinfektionsmitteln und Hautantiseptika nach Standardnormen durch. Mit Ralf Freese haben wir nun einen Prüfarzt und mit Dr. Saskia Borregaard eine GCP-Expertin für den regulatorischen Rahmen ins Team geholt. Beide haben über 15 Jahre Erfahrung bei der Planung, Durchführung und Auswertung klinischer Studien.
So können wir auf GCP (Good Clinical Practice)-Niveau mit einem aktuellen SOP-System von der Idee, der Studienkonzeption mit sinnvollen, hilfreichen und realistischen mikrobiologische Endpunkten durch unseren Experten Dr. Florian H. H. Brill, dem Schreiben des Studienprotokolls, über die Einreichung bei der Ethikkommission, Rekrutierung und Aufklärung von Proband*innen, Durchführung der Studie, Probenahme bei den Probanden, mikrobiologische Auswertung und Berichtslegung alles aus einer Hand auch für Medizinprodukte- und Arzneimittelstudien anbieten.
Wenn Sie interessiert sind als Proband:in an den Studien teilzunehmen, melden Sie sich gerne HIER.
Wir sind auch offen für Teilschritte, bei denen unsere klinisch-mikrobiologische Erfahrung für Sie hilfreich ist. Wir stehen gern für die Beratung im Rahmen der Studienkonzeption oder als mikrobiologisches Labor zur Verfügung, um im Rahmen klinischer Prüfungen an anderen Studienzentren die Auswertung der Proben zu übernehmen und z.B. Probenahme-Kits zur Verfügung zu stellen. Auch als Studienzentrum inkl. mikrobiologischem Labor, wenn Sie den regulatorischen Part anders abbilden können und wollen, stehen wir selbstverständlich gern zur Verfügung.
Wir übernehmen auf Wunsch die komplette Organisation von der Idee, über die Konzeption und die Einreichung bei der Ethikkommission, der Durchführung der Studie bis zur Auswertung und Interpretation der Daten. Selbstverständlich bieten wir auch den mikrobiologischen Service im Rahmen klinischer Studien an anderen Studienzentren gerne an.
Wir freuen uns auf Ihre Anfragen, die bei uns persönlich von Dr. Florian H. H. Brill mit seinem Team bearbeitet werden.

Schulungen
Wir bieten eine Menge interessante Schulungen rund um die Themen Desinfektion, Reinigung, Sterilisation, allgemeine Mikrobiologie und Hygiene, Aufbereitung von Medizinprodukten und Krankenhaushygiene an. Selbstverständlich stellen wir Kurse auch speziell nach Ihren Anforderungen zusammen. Die Dauer eines Kurses kann von 30 Minuten bis zu 4 Tagen sein, je nach Ihren Wünschen und Bedürfnissen.

Portfolio
Auszug
|
EN DIN EN 1040 DIN EN 1275 DIN EN 14347 DIN EN 13727 DIN EN 13624 DIN EN 14348 DIN EN 17126 DIN EN 14476 |
EN DIN EN 16615 DIN EN 17111 DIN EN 16777 DIN EN 14561 DIN EN 14562 DIN EN 14563 DIN EN 16616 DIN EN 17854 |
Sonstige Ph. Eur. 2.6.12 Ph. Eur. 2.6.13 Ph. Eur. 5.1.3 Ph. Eur. 5.1.2 |
ASTM ASTM E1053 ASTM E2314 ASTM E1837 ASTM D7907 |
ISO ISO 10993-5 ISO 15883-5 ISO 11737-1 ISO 22196 |
